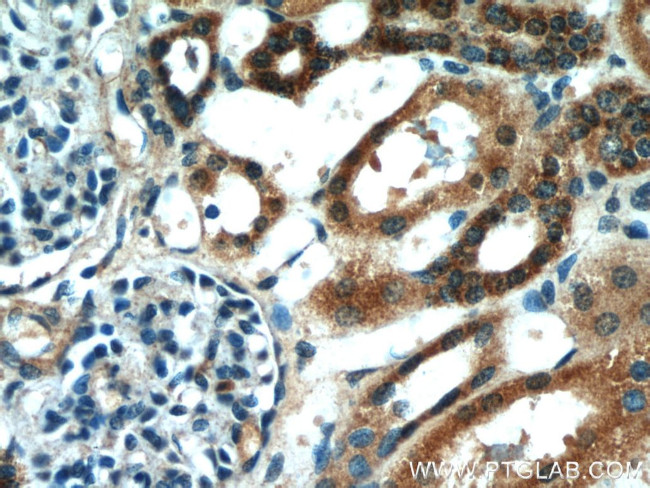
HS3ST1 Antibody in Immunohistochemistry (Paraffin) (IHC (P))

Search
Proteintech
HS3ST1 Polyclonal Antibody
{{$productOrderCtrl.translations['antibody.pdp.commerceCard.promotion.promotions']}}
{{$productOrderCtrl.translations['antibody.pdp.commerceCard.promotion.viewpromo']}}
{{$productOrderCtrl.translations['antibody.pdp.commerceCard.promotion.promocode']}}: {{promo.promoCode}} {{promo.promoTitle}} {{promo.promoDescription}}. {{$productOrderCtrl.translations['antibody.pdp.commerceCard.promotion.learnmore']}}
产品信息
14358-1-AP
宿主/亚型
分类
类型
抗原
偶联物
形式
浓度
规格
保存条件
运输条件
产品详细信息
Immunogen sequence: MAALLLGAV LLVAQPQLVP SRTAELGQQE LLRKAGTLQD DVRDGVAPNG SAQQLPQTII IGVRKGGTRA LLEMLSLHPD VAAAENEVHF FDWEEHYSHG LGWYLSQMPF SWPHQLTVEK TPAYFTSPKV PERVYSMNPS IRLLLILRDP SERVLSDYTQ VFYNHMQKHK PYPSIEEFLV RDGRLNVDYK ALNRSLYHVH MQNWLRFFPL RHIHIVDGDR LIRDPFPEIQ KVERFLKLSP QINASNFYFN KTKGFYCLRD SGRDRCLHES KGRAHPQVDP KLLNKLHEYF HEPNKKFFEL VGRTFDWH (1-307 aa encoded by BC057803)
靶标信息
HS3ST1 is the rate limiting enzyme for synthesis of HSact. HS3ST1 performs the crucial step modification in the biosynthesis of anticoagulant heparan sulfate (HSact) that is to complete the structure of the antithrombin pentasaccharide binding site. Heparan sulfate biosynthetic enzymes are key components in generating a myriad of distinct heparan sulfate fine structures that carry out multiple biologic activities. The enzyme encoded by this gene is a member of the heparan sulfate biosynthetic enzyme family. It possesses both heparan sulfate glucosaminyl 3-O-sulfotransferase activity, anticoagulant heparan sulfate conversion activity, and is a rate limiting enzyme for synthesis of anticoagulant heparan. This enzyme is an intraluminal Golgi resident protein.
仅用于科研。不用于诊断过程。未经明确授权不得转售。